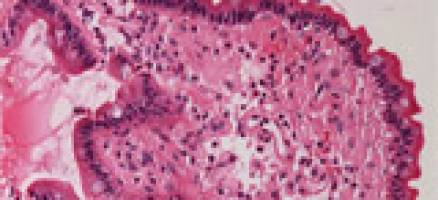
Unfolding amyloid secrets

wire
University of Leeds
Results 801 - 850 of 978.
Pedagogy - 02.09.2011
Partnership website goes live
Economics - 28.01.2011
Industrial action
Economics - 27.01.2011

Researchers from the University of Leeds have shown that an alternative method of industrial cleaning, using diluted acid and super-heated steam, can be used safely on the ancient stonework. The results of the study are now helping a Leeds-based SME to convince sceptical clients of the merits of sand-free cleaning.
Environment - 26.01.2011

A letter published in Nature on 27 January explains how increased melting in warmer years causes the internal drainage system of the ice sheet to 'adapt' and accommodate more melt-water, without speeding up the flow of ice toward the oceans.
Art & Design - 24.01.2011

Life Sciences - Health - 20.01.2011
By pin-pointing the reaction that kick-starts the formation of amyloid fibres, scientists can now seek to further understand how these fibrils develop and cause disease. Amyloid fibres, which are implicated in a wide range of diseases, form when proteins misfold and stick together in long, rope-like structures.
Pedagogy - 19.01.2011

Pedagogy - 19.01.2011

Health - 18.01.2011

- 14.01.2011
Vice-chancellor’s salary
Agronomy & Food Science - Health - 13.01.2011

Environment - Chemistry - 12.01.2011

Under the proposed scheme coal would be burned underground to generate energy, offering a new lease of life to coal seams that are too expensive to mine.
Environment - Earth Sciences - 06.01.2011

The team will be heading to part of the coldest, windiest, highest and driest continent on Earth to hunt for clues that will tell us more about how the glaciers and ice sheets of the north-eastern Antarctic Peninsula behaved in past climates and what we can expect in the future.
Economics - Environment - 04.01.2011

Many UK power stations are now burning plant matter, or biomass, as well as coal in a bid to cut their carbon footprint.
Economics - 04.01.2011

Physics - Mechanical Engineering - 31.12.2010

Economics - Administration - 22.12.2010

Environment - Agronomy & Food Science - 22.12.2010

- 22.12.2010
Pensions scheme consultation next steps
Read more news Published Wednesday 22nd December 10 The consultation regarding changes to the USS pension scheme finishes today, 22 December 2010.
Health - Life Sciences - 20.12.2010

Around 50,000 people in the UK are currently taking lithium. When used appropriately, lithium can be a good way to prevent mood swings caused by bipolar disorder, combating mania, or treating severe and recurring bouts of depression.
Economics - 16.12.2010

Health - Pedagogy - 16.12.2010

History & Archeology - Life Sciences - 15.12.2010

Economics - 15.12.2010

Health - Life Sciences - 14.12.2010

The project has been awarded $500,000 from the Bill and Melinda Gates Foundation, through the World Health Organisation, and aims to be effective against all polio subtypes.
Chemistry - Environment - 13.12.2010

The colours run, leaving both your black top and your white shirt looking different shades of grey. But now scientists at the University of Leeds have invented a revolutionary way of permanently colouring the molecules of fabric fibres, meaning that the colours never run and clothes never fade.
Health - Economics - 13.12.2010

Environment - 10.12.2010
University of Leeds response to tuition fees vote
Health - Linguistics & Literature - 07.12.2010
Rupert Beckett Lecture Theatre occupation
Health - Life Sciences - 06.12.2010

Professor J Anthony Child and Professor Walter M Gregory (Clinical Trials Research Unit (CTRU), University of Leeds), Professor Gareth J Morgan (formerly at the University of Leeds), together with colleagues from universities and NHS Trusts across the UK, compared two different types of bisphosphonate drug in patients with multiple myeloma.
Economics - Health - 03.12.2010

Linguistics & Literature - 03.12.2010
University of Leeds statement on Rupert Beckett ventilation
Read more news Published Friday 3rd December 10 Claims that the University has switched off the heating by occupiers of the Rupert Beckett Lecture Theatre are untrue, as are claims about setting off fire alarms.
Linguistics & Literature - 03.12.2010

Event - 02.12.2010

Linguistics & Literature - 02.12.2010

Economics - Computer Science - 02.12.2010

PC-based virtual reality training is typically cheaper than face-to-face sessions with a mentor or coach.
- 01.12.2010

Chemistry - Life Sciences - 30.11.2010

Environment - Earth Sciences - 30.11.2010

Life Sciences - Physics - 26.11.2010

The plaque, which has generously been sponsored by the Thackray Museum, will be unveiled today on Astbury's former Headingley home, in the presence of his family and representatives of Leeds Civic Trust, the Thackray Museum and the University of Leeds.
Environment - Civil Engineering - 23.11.2010

The £1.5 million STEP-CHANGE project, funded by the Engineering and Physical Sciences Research Council (EPSRC), aims to inform a 'step-change' in attitudes to urban transport by revolutionising the planning of towns and cities.
Linguistics & Literature - 22.11.2010

Linguistics & Literature - 16.11.2010

The exhibition presents Beardsley's black and white fantasy world - at once wondrous, monstrous, and exotic - in context, celebrating the richness and variety of the medium of book illustration in Britain, during the vibrant period between 1890 and the 1920s.
Environment - Economics - 15.11.2010

The university's achievements will be celebrated with the launch of a new publication highlighting ten of the ways its projects have had a lasting positive impact on the world and in particular, on the issue of sustainability.
Economics - 15.11.2010
Losses from counterfeiting cost region £537 million per annum
Social Sciences - Law - 12.11.2010

Environment - Economics - 11.11.2010

The university's achievements will be celebrated with the launch of a new publication highlighting ten of the ways its projects have had a lasting positive impact on the world and in particular, on the issue of sustainability.
Health - Chemistry - 11.11.2010

Environment - Economics - 09.11.2010

Ouruplands.co.uk , which launches today, will tell the story of the UK uplands and give people who live and work there a unique platform to express their views.
Pedagogy - 03.11.2010
Response to David Willetts statement on higher education
Campus - GLASGOW - Mar 16
Evidence from five decades of graduates confirms Humanities skills power careers and lifelong impact
Evidence from five decades of graduates confirms Humanities skills power careers and lifelong impact
Health - Mar 13
Oxford and Serum Institute of India sign IP license agreement to advance NipahB vaccine candidate
Oxford and Serum Institute of India sign IP license agreement to advance NipahB vaccine candidate



